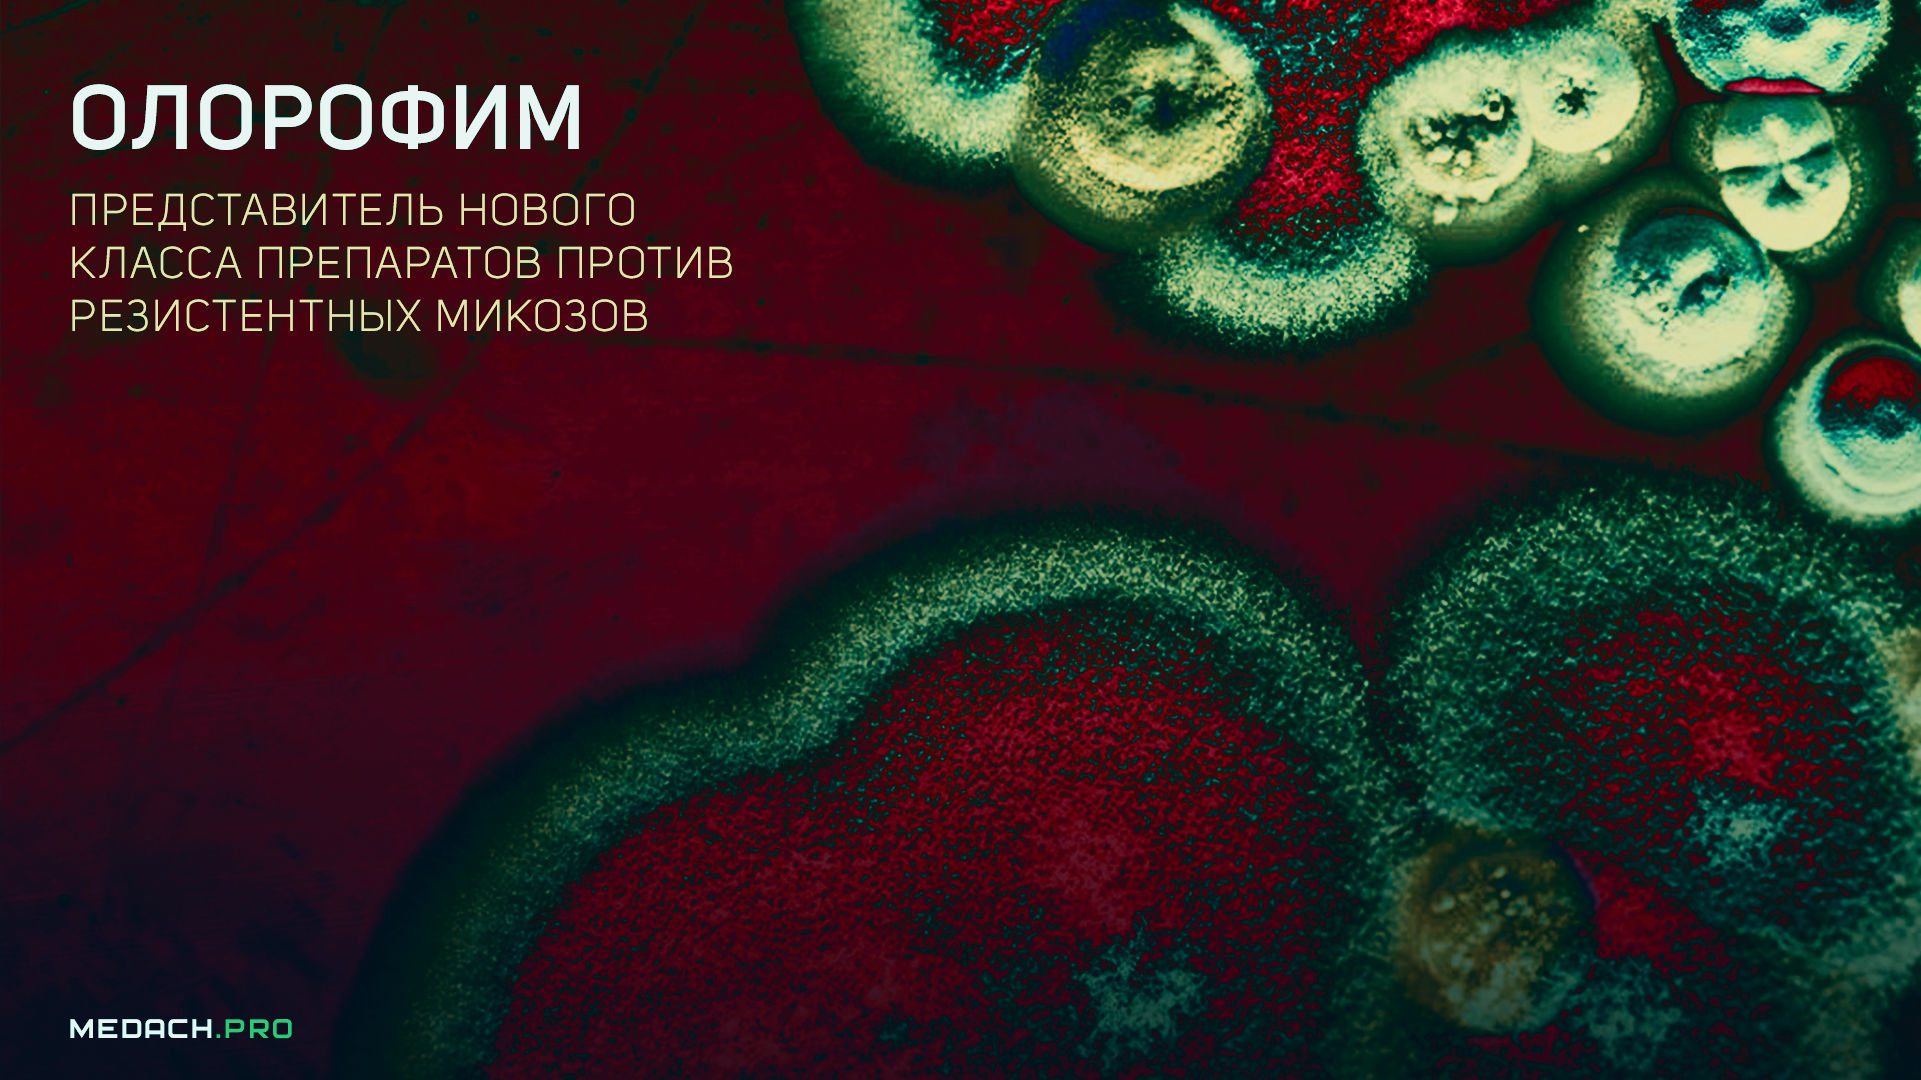

Олорофим — новый класс препаратов против резистентных микозов
новостьмикозыантимикотикиФармакологияинфекцииМикробиологияаспергиллезОригиналПеревод: Alex HiverРедакция: Алексей Недосугов, Cornu AmmonisОформление: Cornu AmmonisПубликация: 14.08.2025
Очевидно, что назрела острая необходимость в новых противогрибковых препаратах, не только в плане расширения спектра действия, но и улучшения биодоступности при приеме внутрь, переносимости и межлекарственного взаимодействия. В настоящее время растет обеспокоенность по поводу возникновения резистентности к имеющимся в настоящее время противогрибковым препаратам, вызванной преимущественно использованием сельскохозяйственных фунгицидов или противогрибковых препаратов длительного воздействия в условиях профилактики плесени, или хронических противогрибковых инфекций, таких как хронический легочный аспергиллез. Более того, из-за внедрения профилактики (плесени) увеличивается частота вспышек инфекций (1-4). Появляются трудно поддающиеся лечению инвазивные грибковые инфекции, такие как Lomentospora prolificans, или вызываемые скрытыми видами Aspergillus, Scedosporium и Coccidioides.
Олорофим (F901318) является первым в классе оротомидов, нового класса противогрибковых препаратов, нацеленных на дигидрооротат дегидрогеназу (ДОДГ) (да, как лефлуномид — прим.ред.), ключевой фермент в биосинтезе пиримидинов. Олорофим демонстрирует хорошую активность in vitro и in vivo против видов Aspergillus, редких и трудно поддающихся лечению плесневых грибов и эндемичных диморфных грибов, включая азол- и амфотерицин-устойчивые изоляты. Он неактивен против дрожжей и видов рода Mucorales. Это препарат для перорального приема, и он демонстрирует многообещающие результаты в текущих клинических испытаниях. В этой работе описан механизм действия олорофима, спектр активности in vitro и in vivo и клинические результаты.
Предыстория
В 2022 году ВОЗ опубликовала первый список приоритетных патогенных грибков. Candida albicans, Aspergillus fumigatus, Candida auris, Cryptococcus neoformans считаются критически важными. Fusarium spp., Candida tropicalis, Candida parapsilosis, Candida glabrata, Histoplasma capsulatum и грибы, вызывающие мукормикоз или мицетому, считаются особо важными в этом перечне [5]. Виды Aspergillus являются наиболее важными возбудителями инвазивных плесневых инфекций, которые ежегодно поражают более 2100000 человек во всем мире [6,7,8]. Появляются трудно поддающиеся лечению инфекции, такие как вызванные Lomentospora prolificans, криптическими видами Aspergillus, Mucorales и другими редкими инвазивными грибковыми заболеваниями (ИГЗ) [5, 9-22]. За последние двадцать лет с момента введения триазолов в качестве терапии первой линии и благодаря улучшению диагностики и поддерживающей терапии улучшилась выживаемость пациентов с инвазивным аспергиллезом (ИА) [23-27]. Особо высокому риску подвергаются пациенты с тяжелой нейтропенией и тяжелой реакцией «трансплантат против хозяина» (РТПХ). Однако ИГЗ возникают у большего числа пациентов как с ослабленным, так и не ослабленным иммунитетом, находящихся в группе риска, отчасти из-за новых методов противораковой терапии и трансплантации солидных органов, а также у пациентов в критическом состоянии с тяжелой (вирусной) пневмонией и у пациентов с хронической обструктивной болезнью легких (ХОБЛ) [8, 28-36].
В настоящее время в клинической практике для лечения ИГЗ используются четыре класса противогрибковых препаратов. Перечислим эти классы:
- полиены, такие как липосомальный амфотерицин B (AmB),
- триазолы, такие как флуконазол, итраконазол, вориконазол, позаконазол и изавуконазол,
- эхинокандины, такие как каспофунгин, анидулафунгин и микафунгин,
- антиметаболиты, такие как 5-фторцитозин [29, 37-43].
Схематический обзор механизмов их действия показан на рис. 1.

Рисунок 1 | Текущий арсенал противогрибковых препаратов и механизм действия олорофима
Липосомальный AmB является широко используемым противогрибковым средством, служащим основным вариантом лечения некоторых ИГЗ, таких как мукормикоз и криптококкоз. Однако использование липосомального AmB остаётся ограниченным в связи с его токсичностью и исключительно парентеральным способом введения, что также применимо к эхинокандинам, другим классом противогрибковых препаратов, обладающих пониженной эффективностью против видов Aspergillus [44, 45]. Триазолы проявляют важные лекарственные взаимодействия (в частности, у позаконазола, вориконазола и итраконазола) и гепатотоксичность [46, 47]. Более того, растет беспокойство по поводу противогрибковой резистентности к существующим ныне азольным противогрибковым препаратам, которая обусловлена, преимущественно, использованием сельскохозяйственных фунгицидов или длительным воздействием противогрибковых препаратов в контексте активной профилактики поражений плесневыми грибками или как средства лечения хронических противогрибковых инфекций, таких как хронический легочный аспергиллез (ХЛА) [1-4, 48-54]. Устойчивость к азолам связана и с высокой общей смертностью у пациентов с ИА [3, 50, 52, 55].
В заключение следует отметить растущую потребность в противогрибковых препаратах, принимающую во внимание спектр их активности, включающий устойчивость, токсичность, межлекарственные взаимодействия и способ введения. Приведем ряд новых противогрибковых препаратов на разных стадиях клинической разработки: фосманогепикс (ингибитор фермента Gwt1), ибрексафунгерп (тритерпеноид), опелконазол (азол, оптимизированный для ингаляции), резафунгин (эхинокандин с длительным периодом полураспада), AM2-19/SF001 (полиен со щадящим влиянием на почки) [56], MAT2203 (пероральный энкохлеированный амфотерицин B) [57] и олорофим (ингибитор ДОДГ) [58].
Олорофим — недавно разработанный противогрибковый препарат нового класса оротомидов, воздействующий на фермент ДОДГ грибков. Препарат был разработан компанией F2G Biotech GmbH (Манчестер, Англия) и в настоящее время проходит испытания III фазы (NCT05101187). Европейское агентство по лекарственным препаратам (EMA) и Управление по контролю за качеством продуктов питания и лекарственных средств (FDA) присвоили ему статус орфанного препарата, статус квалифицированного препарата для лечения инфекционных заболеваний и статус революционного препарата для лечения различных инвазивных грибковых инфекций.
Механизм действия
Олорофим был выделен из библиотеки потенциальных лекарств, содержащей 340 000 малых молекул, посредством скрининга на предмет in vitro активности против Aspergillus fumigatus [59].
Дигидрооротат дегидрогеназа является единственным ферментом-оксидоредуктазой среди шести ферментов, катализирующих биосинтез пиримидина; ДОДГ катализирует четвертый этап пути биосинтеза пиримидина – превращение дигидрооротата в оротат [59, 60]. Пиримидины необходимы для синтеза ДНК и РНК и участвуют в образовании предшественников метаболизма липидов и углеводов. Выделяют два класса ДОДГ – класс I и II – на основе аминокислотной последовательности, расположения внутри клетки и предпочтимости субстрата. У большинства патогенов содержатся ДОДГ класса II, которая связана с внутренней мембраной митохондрий. Фермент содержит N-концевой спиральный домен и C-концевой домен. N-концевой домен сворачивается в две альфа-спирали, которые образуют канал к активному сайту и являются сайтом связывания для ингибиторов ДОДГ II класса [61, 62].
Олорофим действует как обратимый ингибитор и ингибирует ДОДГ, связываясь с N-концевым спиральным доменом ДОДГ у A. fumigatus. Оротомиды связываются в вышеупомянутом канале, по которому убихинон входит в фермент из внутренней митохондриальной мембраны, предотвращая повторное окисление кофактора дигидрофлавинмононуклеотида (FMNH2), необходимого для протекания реакции. ДОДГ человека всего лишь примерно на 30% идентична своему грибковому гомологу и ингибируется олорофимом в 2000 раз менее эффективно [59]. Это ингибирование нарушает образование уридин-5′-монофосфата (УМФ) и уридин-5′-трифосфата (УТФ), необходимых предшественников для клеточных процессов. УТФ особенно важен для биосинтеза УДФ-сахаров, выступая в качестве субстратов для хитинсинтетазы и 1,3-β-D-глюкансинтазы — основных ферментов, ответственных за синтез компонентов клеточной стенки грибка хитина и 1,3-β-D-глюкана соответственно. УМФ и УТФ также важны для синтеза цитозина, тимина и урацила, а также для регуляции клеточного цикла [63].
Исследование in vitro показало, что конидии A. fumigatus, обработанные олорофимом, не прорастали, однако изотропный рост продолжался. Это подтверждает точку зрения, что синтез пиримидина de novo для изотропного роста не требуется, но необходим для прорастания. Более того, олорофим также подавляет поляризованный рост гиф A. fumigatus in vivo. Длительное воздействие олорофима приводит к ингибированию поляризованного роста гиф, набуханию и лизису. Таким образом, олорофим убивает A. fumigatus времязависимо, при этом длительное воздействие приводит к лизису гиф (34 ч) и к гибели клеток через 120 ч. Даже после более коротких по времени воздействий гифы, по всей видимости, с трудом восстанавливаются [64]. Известно, что пролиферирующим клеткам требуется активный биосинтез пиримидина de novo [65, 66]. Эти наблюдения подтверждают гипотезу о том, для изотропного роста конидий что синтез пиримидинов de novo не требуется, но он жизненно важен для прорастания. Кроме того, кажется, что для поляризованного роста гиф необходимо присутствие достаточного количества пиримидинов [64]. Помимо синтеза de novo грибы также способны получать пиримидины из окружающей среды. Анализы восприимчивости in vitro показывают, что добавление экзогенных пиримидинов обращает вспять активность олорофима, однако это происходит только при концентрациях пиримидинов ≥ 5 мМ. Эти концентрации намного выше, чем концентрация, обнаруженная в сыворотке крови человека (около 15 мкМ). Следовательно, пиримидина, поглощенного грибами из сыворотки, будет недостаточно, чтобы отменить эффект олорофима у пациента [59].
Вакуоли играют важную роль в размере клеток и в регуляции клеточного цикла [67, 68]. Другое исследование in vitro показало, что вакуоли в гифах, подвергшихся воздействию олорофима, значительно увеличились в размере [69]. Увеличение вакуолей может быть связано с остановкой клеточного цикла, поскольку объем цитоплазмы может быть важным триггером для G1-фазы, в которой происходит синтез мРНК и белков в рамках подготовки к митозу. Большие вакуоли образуются в условиях ограниченности питательных веществ с целью уменьшения объема цитоплазмы, и это снижает потребность в питательных веществах и синтезе белков [68]. Предполагается, что образование больших вакуолей может быть признаком активации аутофагии [69].
Наконец, обработка олорофимом приводит к увеличению количества септ [в гифах грибов] и ремоделированию клеточной стенки с уменьшением бета-1-3-глюкана на кончиках гиф и увеличением содержания хитина во всем мицелии [69]. Это может быть связано с компенсаторным механизмом, который, как уже известно, запускается при снижении уровня 1,3-β-d-глюкана после воздействия эхинокандина на различные виды грибов [70,71,72].
Спектр активности
Олорофим демонстрирует уникальный спектр активности. Схематический обзор показан на рис. 2. Этот уникальный спектр активности олорофима объясняется различиями в ферментах ДОДГ среди различных групп грибов [59]. Несмотря на то, что эти ДОДГ относятся ко II классу, ферменты, полученные из видов Candida и Cryptococcus, по всей видимости лишь отдаленно связаны с ДОДГ грибов, восприимчивых к ингибированию олорофимом [59]. У видов Mucorales содержатся только ДОДГ класса IA и, таким образом, отсутствуют ДОДГ класса II, который является мишенью олорофима. Некоторые виды дематиевых плесневых грибков демонстрируют смешанную восприимчивость к олорофиму, вероятно, потому, что они содержат дигидроурацилоксидазы, а не ДОДГ [73]. Олорофим не проявляет активности in vitro против дрожжей (видов рода Candida [70] и Cryptococcus [74]), Mucorales — термически мономорфных плесневых грибов, Alternaria alternata [75] и Exophilia dermatitidis [76].

Рисунок 2 | Спектр олорофима.
In vitro
Олорофим демонстрирует активность против нескольких грибков, которые либо резистентны, либо характеризуются сниженной восприимчивостью к существующим противогрибковым препаратам: против всех видов Aspergillus, включая криптические виды и изоляты, резистентные к азолам или устойчивым к AmB (например, A. lentulus, A. fumigati affinis, A. novofumigatus, A. thermomutatus, A. calidoustus, A. flavus, A. nidulans, A. tubigensis, A. terreus, A. udagawae, A. fumisynnematus, A. tanneri, A. pseudoviridinutans, A. versicolor и др.) [51, 64, 70, 75-89]. Олорофим даже проявляет значительную ингибирующую активность на ранней стадии роста A. fumigatus, A. flavus и A. niger при концентрациях препарата более чем в 100000 раз ниже МПК [90]. Он активен против эндемичных микозов, таких как Coccidioides immitis, Histoplasma capsulatum, Blastomyces dermatitidis и виды рода Sporothrix (виды brasiliensis, globosa, schenckii) [59, 91-93]. Препарат также проявляет активность против видов Lomentospora prolificans и Scedosporium [59, 76, 77, 94,95,96,97,98]. Виды Fusarium демонстрируют различную восприимчивость к олорофиму, препарат не проявляет активности против F. dimerum, но проявляет хорошую активность против F. verticilloides, F. fujikuroi и F. proliferatum и изменчивую активность против F. solani и F. oxysporum [49, 74, 77, 78, 99,100,101]. Кроме того, in vitro отмечается активность против Microascus/Scopulariopsis, Penicillium, Paecilomyces, Purpereocillium, Rasamsonia, Talaromyces, Trichophyton (включая T. indotineae и другие устойчивые к тербинафину изоляты [75]) и Madurella mycetomatis, наиболее распространенной этиологической причины эумикотической мицетомы [59, 70,75-78,102-106]. Интересно, что олорофим также проявляет активность против биопленок Aspergillus fumigatus и Lomentospora prolificans, как показано in vitro [95, 107].
In vivo
Активность олорофима in vivo определялась в нескольких мышиных моделях аспергиллеза, кокцидиоидомикоза, ломеноспориоза и сцедоспориоза.
В мышиной модели инвазивного легочного аспергиллеза (ИЛА) с нейропенией, животных инфицировали хорошо известным штаммом A. fumigatus (NIH 4215). При лечении олорофимом выживаемость значительно улучшилась, даже для штаммов с резистентностью к азолам из-за мутаций CYP51A [59]. В другой мышиной модели ИЛА с нейтропенией лечение олорофимом привело к значительному увеличению выживаемости мышей, инфицированных как азол-чувствительными, так и азол-резистентными (мутированными TR34/L98H и G138C) изолятами A. fumigatus, и наблюдалось значительное дозозависимое снижение сывороточного галактоманнана (ГМ) по сравнению с животными, которым воодили гуманизированную дозу позаконазола [81]. Аналогичные результаты были получены в мышиной модели синопульмонального аспергиллеза, вызванного A. flavus, где олорофим продемонстрировал дозозависимое снижение ГМ, а также повышенную выживаемость, большую, чем в случае с позаконазолом. Также наблюдалось дозозависимое гистопатологическое очищение легочной ткани от грибков [80]. Был проведен эксперимент с другой мышиной моделью животных с нейтропенией с диссеминированным аспергиллезом, вызванным Aspergillus terreus. Олорофим продемонстрировал более продолжительную выживаемость у этих мышей, превосходящую таковую в случае использования AmB, и привел к снижению гистопатологической грибковой нагрузки в почечной ткани [82]. В мышиных моделях инвазивного аспергиллеза у нейтропенических мышей CD-1 и мышей с хроническим гранулематозным заболеванием (мыши линий gp−/− phox), инфицированных A. fumigatus, A. nidulans или A. tanneri, лечение олорофимом (интраперитонеально) привело к улучшению выживаемости, снижению уровня ГМ и снижению грибковой нагрузки, что измерялось с помощью количественной ПЦР (ДНК) и с помощью методов гистопатологии, независимо от восприимчивости видов Aspergillus к азолам. В контрольной группе выжили в течение 10 дней выжили менее 10% мышей [108].
Для модели центрального кокцидиоидомикоза у мышей артроконидии C. immitis были инокулированы внутрь черепа животных. В результате лечения олорофимом значительно улучшилась выживаемость и снизилась грибковая нагрузка на мозг по сравнению с контрольной группой (и было времязависимо), что определялось по колониеобразующим единицам. Выживаемость животных увеличилась, а грибковая нагрузка в мозговой ткани снизилась, когда частота дозирования олорофима была увеличена с двух раз в день до трех раз в день, несмотря на отсутствие изменений в общих суточных дозах [93].
Наконец, в модели циклофосфамид-иммуносупрессированных мышей CD-1 с нейтропенией, животных инфицировали Scedosporium apiospermum, Pseudallescheria boydii (Scedosporium boydii) и Lomentospora prolificans и лечили интраперитонеальным введением олорофима. Лечение олорофимом значительно улучшило выживаемость по сравнению с контрольной группой. Уровни бета-D-глюкана (BDG) и грибковая ДНК-нагрузка в значительной степени были подавлены, что было подтверждено гистопатологически, поскольку в почках мышей было выявлено лишь незначительное (или вообще отсутствовало) поражение гифами грибков [109].
Клинические результаты
Данные открытого одногруппового исследования IIb фазы FORMULA-OLS/Исследование 32 (NCT03583164) включают пациентов с ИГЗ, вызванными Lomentospora prolificans, Scedosporium spp., Aspergillus spp. и другими резистентными грибами, у которых отсутствуют подходящие альтернативные варианты лечения. В исследование было включено 202 пациента (“модифицированная популяция начавших лечение пациентов”), среди которых с Aspergillus spp. (группа с подтвержденным или вероятным ИА) был 101 человек, включая 22 случая с азол-резистентными штаммами, а также лица с инфекциями Lomentospora prolificans [26], Scedosporium spp. [22], Coccidioides spp. [41], Scopulariopsis spp. [6] и другими грибами, такими как Fusarium или Madurella spp. [8]. Общий показатель успешности на 42-й и 84-й день составил 28,7% и 27,2%, и 34,7% и 33,7% соответственно для общей когорты и ИА. Общий показатель успешности для не-кокцидиомикозных ИГЗ (n = 161) составил 36,0% на 42-й день. Смертность от всех причин на 42-й и 84-й день составила 11,4% и 15,8% для общей когорты и 17,8% и 25,7% для ИА, соответственно. Если стабилизацию состояния считать успехом, что, безусловно, приемлемо с клинической точки зрения при подобных трудно поддающихся лечению инфекциях, то показатель успешности составил 75,2% на 42-й день и 63,4% на 84-й день [130]. Для Coccidioides spp. на 42-й и 84-й день ответа не было, так как это можно оценить только с помощью подтвержденной эрадикацией грибка. Тем не менее, клиническая польза была получена у 75,6% и 73,2% на 42-й и 84-й день соответственно [124].
В дополнение к этому исследованию IIb фазы, имеются довольно ограниченные клинические данные из отчетов о клинических случаях и одной серии случаев. Три отчета о клинических случаях показали положительные клинические результаты у пациентов с инвазивным ломентоспориозом.
В одном случае речь шла о 56-летней женщине с диссеминированным ломентоспориозом после получения интенсивной химиотерапии по поводу Т-клеточного острого лимфобластного лейкоза (T-ALL), которая не дала результата на вориконазоле в сочетании с тербинафином и хирургической циторедукцией позвоночника. Улучшение наблюдалось в течение 6 месяцев после начала лечения олорофимом [131].
Во втором случае описана 49-летняя женщина с обширным ломентоспориозом правого грудного имплантата, отсутствием результата хирургического вмешательства, резистентностью к вориконазолу, тербинафину, позаконазолу, милтефозину и анидулафунгину. После начала приема олорофима наблюдалось постепенное клиническое улучшение течения инфекции [132].
В третьем случае сообщается о 57-летнем реципиенте трансплантата легкого, находящемся на активной иммуносупрессии, с диссеминированной инфекцией и эндофтальмитом, вызванным Lomentospora prolificans; пациент систематически лечился вориконазолом, тербинафином и микафунгином. Позднее пациенту был назначен олорофим, частично в сочетании с вориконазолом и тербинафином, и первоначально наблюдалась хорошая реакция на терапию с возможностью выписки, но в конечном итоге наступила смерть из-за прогрессирования заболевания. Тест на восприимчивость к олорофиму на положительной культуре не проводился [133].
Другой отчет о случае описывает 45-летнего мужчину с распространенным кокцидиомикозом, поразившим в том числе и ЦНС. Лечение флуконазолом, вориконазолом, итраконазолом, позаконазолом и микафунгином не дало результата. Затем была начата комбинированная терапия позаконазолом и олорофимом с последующим быстрым клиническим улучшением и снижением титра связывания комплемента [134].
Применение олорофима также оказалось успешным у 14-летнего пациента мужского пола с ИЛА, с сопутствующим Х-сцепленным хроническим гранулематозным заболеванием. В ходе биопсии легкого была обнаружена грибковая культура A. fumigatus с множественной резистентностью к азолам из-за мутации в гене CYP51A. У пациента наблюдалась рефрактерность к терапии, несмотря на лечение вориконазолом и каспофунгином. Из-за резистентности был назначен липосомальный AmB, что привело к частичной регрессии ИЛА. Однако из-за нефротоксичности курс AmB был прекращен, и была проведена операция. После курса олорофима (первоначально в сочетании с каспофунгином) наступила полная и длительная ремиссия [135].
Наконец, серия клинических случаев описывает трех пациентов с рефрактерной бронхолегочной инфекцией Microascus spp., которых лечили олорофимом. Среди них был 17-летний мальчик в условиях политравмы, которого успешно пролечили комбинацией олорофима и тербинафина от легочной инфекции M. melanosporus. Двое оставшихся пациентов были реципиентами трансплантата легких, которых успешно лечили олорофимом (в случае с последним пациентом — в сочетании с тербинафином) от легочной инфекции M. cirrosus [136].
Таким образом, у нас на подходе молекуляа против случаев резистентного аспергиллеза и, возможно, других микозов, например Lomentospora иScedosporium. Ждем результатов эффективности и безопасности в новых исследованиях.